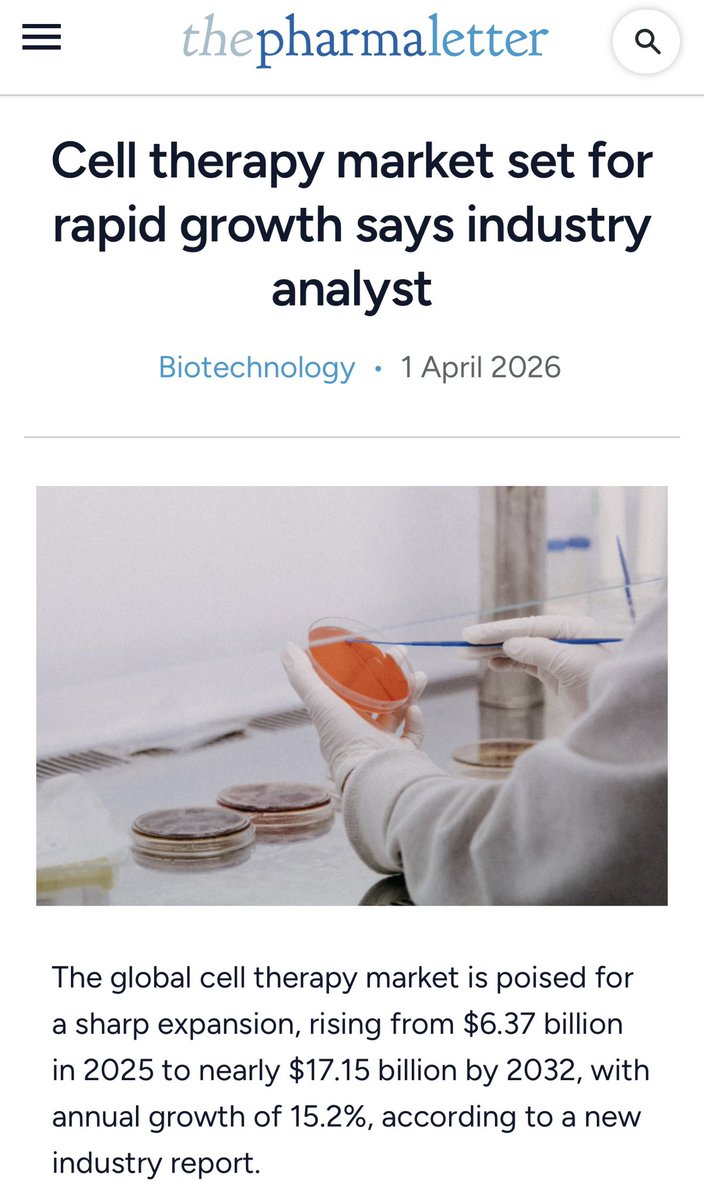
ATLnsider tweet media

Peter Davis
13.2K posts

Peter Davis
@peter_brit
Disclaimer: I am not a financial advisor. Conduct your own due diligence. Regulatory outcomes are subject to clinical data and agency discretion.







#dcvax $nwbo #gbm interesting Gemini AI Analysis of DCVax eligibility evaluation: The launch of the MHRA-NICE Aligned Pathway on April 1, 2026, is a highly relevant development for DCVax-L. This pathway is specifically designed to eliminate the "90-day gap" between a drug getting its license and getting NHS funding approval. Based on the criteria and current status of DCVax-L, here is an evaluation of its eligibility: 1. High Eligibility for the "Innovation" Criteria The pathway is intended for medicines that address unmet clinical needs and are transformative. DCVax-L fits these criteria exceptionally well: Unmet Need: Glioblastoma (GBM) has had no major new standard-of-care treatments in nearly two decades. Innovation: As a personalized immunotherapy using a patient’s own dendritic cells, it is exactly the kind of "step-change" technology the government’s 10-Year Health Plan aims to fast-track. 2. Status of the NICE Appraisal (ID836) DCVax-L is already in the NICE system (Project ID836). According to the new pathway rules: Automatic Transition: Since October 2025, topics submitted to NICE for scheduling can follow the aligned pathway. Current Progress: NICE updated the DCVax-L project page as recently as April 2025, indicating the evaluation is "In Progress." Because the appraisal is active but a final decision has not yet been published, it is a prime candidate for this "simultaneous decision" model. 3. Requirements for Eligibility To fully utilize this specific pathway, Northwest Biotherapeutics (NW Bio) would need to meet certain administrative milestones: UK PharmaScan: The manufacturer must have registered the product on UK PharmaScan (the database for upcoming medicines). Early Engagement: The pathway encourages "Integrated Scientific Advice" 2 to 5 years before marketing authorization. While DCVax-L is already in the late stages, the new pathway allows for parallel processing where NICE committee meetings happen in public before the MHRA even grants the license.+1 Simultaneous Publication: If eligible, the goal would be for the MHRA to grant the license and NICE to publish its "Green Light" for NHS funding on the exact same day. 4. Synergy for the Platform Technology If DCVax-L (the "L" for Lysate) is successfully processed through this aligned pathway, it creates a "regulatory blueprint" for the rest of the DCVax platform: DCVax-Direct: Future variations of the platform could use the Integrated Scientific Advice service mentioned in the blog to align trial endpoints with what NICE requires for cost-effectiveness from the start. UK as a Hub: The pathway is part of a broader strategy to make the UK the "most attractive place to invest in life sciences." For a company like NW Bio, which has invested heavily in UK infrastructure (the Sawston facility), this pathway justifies that investment by providing a faster route to revenue. Conclusion Yes, DCVax-L is highly eligible. In fact, it is the exact type of "complex, high-impact" medicine the MHRA-NICE Aligned Pathway was built to handle. The main hurdle is whether the manufacturer has provided enough "timely notification" and data to NICE to keep pace with the MHRA review. If they have, patients could see DCVax-L available on the NHS 3 to 6 months sooner than under the old system. (Gemini AI Analysis)

#dcvax $nwbo #gbm Changes to NICE’s cost-effectiveness thresholds take effect: NICE has implemented new measures to evaluate the cost-effectiveness of medicines, following a policy change that aims to give patients improved access to treatments. "When we evaluate a new medicine or piece of tech for the NHS to use, we use quality-adjusted life years (QALYs) to estimate the health benefits. The QALY combines both the length of life gained from a treatment and its impact on quality of life. We use QALYs to compare new potential treatments with the treatment already available through the NHS.In a health service funded through general taxation, it is right that government decides on the level of health and medicines spend. The new thresholds aim to provide better outcomes for patients, while also supporting the life sciences sector and broader economy.Our independent appraisal committees will use the new thresholds immediately, and these changes will be applied to both new and on-going medicines evaluations." (Professor Jonathan Benger, NICE chief executive) "These changes follow the government’s decision to increase the thresholds that NICE can use in technology appraisals to £25,000 - £35,000 per quality-adjusted life year gained" Gemini AI Analysis of relevance and synergy with DCVax platform technology: The news article you referenced (published April 2, 2026) regarding the increase in NICE's cost-effectiveness thresholds marks a significant shift in the UK healthcare landscape. For a "platform technology" like DCVax-L (developed by Northwest Biotherapeutics), these changes create a high degree of synergy and improved relevance for its upcoming http://appraisal. Here is an analysis of how the new NICE thresholds interact with the DCVax platform: 1. Direct Impact of the Threshold Increase The Change: NICE has increased its standard cost-effectiveness threshold from £20,000–£30,000 to £25,000–£35,000 per Quality-Adjusted Life Year (QALY). Relevance to DCVax: As a personalized immunotherapy, DCVax-L is a "high-touch" technology involving leukapheresis, clean-room manufacturing, and specialized administration. These processes typically carry higher price points than traditional small-molecule drugs. The higher threshold provides more "headroom" for DCVax-L to be deemed cost-effective, even with the intensive costs of personalization. 2. Synergy with the "Severity Modifier" NICE recently replaced the "End of Life" criteria with a broader Severity Modifier. This is highly synergistic with DCVax for two reasons: Glioblastoma (GBM) Severity: GBM is one of the most aggressive and fatal forms of cancer, with a very high "absolute and proportional QALY shortfall." Under the 2026 framework, technologies treating such severe conditions can receive a weighting of 1.2x or 1.7x to their QALY gains. Multiplier Effect: When you combine the increased base threshold (£35k) with the severity modifier (up to 1.7x), the effective threshold for a drug like DCVax-L could potentially reach £59,500 per QALY. This significantly lowers the barrier for a complex platform technology to achieve a positive recommendation. 3. "Platform Technology" Benefits: Life-Cycle Value The article emphasizes supporting innovation. DCVax is not just a single drug but a platform technology: Adaptability: The same DCVax process (using dendritic cells) can be "loaded" with different antigens (DCVax-Direct for in-situ tumors or DCVax-L for lysates). Cost Efficiency over Time: Once the NHS establishes the infrastructure for one DCVax application (e.g., in Glioblastoma), the marginal cost of expanding to other indications (Prostate, Ovarian, etc.) may decrease. The new NICE focus on "supporting the life sciences sector" aligns with rewarding technologies that provide a foundation for multiple future treatments. 4. Clinical Evidence Synergy The 2026 threshold change is timed alongside the maturation of DCVax-L's Phase III data, which showed: Long-term Survivors: A "tail" on the survival curve (13% of newly diagnosed patients surviving 5 years). NICE’s updated methods are increasingly sensitive to capturing the value of "long-term survival" and "cure" possibilities, which are often undervalued by old-fashioned linear http://models. Safety Profile: Because DCVax-L has a very low toxicity profile compared to chemotherapy, it maintains a higher "Quality of Life" (QoL) for patients. In a QALY-based system, a high QoL multiplier combined with extended life (Overall Survival) makes the "value" side of the equation much stronger. For stakeholders in Northwest Biotherapeutics, this policy shift represents the removal of one of the largest historical hurdles to UK market access. nice.org.uk/news/articles/…


NICE has implemented new measures to evaluate medicine cost-effectiveness, following a policy change increasing evaluation thresholds to £25,000–£35,000 per quality-adjusted life year gained — improving patient access to treatments. Learn more: nice.org.uk/news/articles/…

$NWBO 10K of last year mentioned that $NWBO in-licensed a different type of immune booster that BP has been trying for years to develop as a treatment itself. Is it some kind of oncolytic virus since several BPs have oncolytic virus program for cancer treatment? Now I am wondering if 'V' in Dr. Bosch's NYAS presentation may stand for V937. sec.gov/ix?doc=/Archiv… The Company has been in discussions since mid-2024 with a different company to in-license a different type of booster agent – one that big pharma has been trying for years to develop as a treatment itself. The Company executed a Material Transfer Agreement with that company and has been testing samples of this agent in internal lab research as described below. The Company has also been in negotiations since early Q4 2024 for potential acquisition of another company with a dendritic cell related technology. The Company hopes to complete these negotiations during Q2 or Q3 2025.

#dcvax $nwbo #gbm Launching 8 April: i4i PDA RWE NICE EVA funding opportunity Webinar: 15 April 2026, 1–2:30pm Gemini AI Analysis of importance, synergy and relevance to DCVax platform technology: 4. Strategic Timing "The timing of this call (opening April 2026) aligns with the expected progression of DCVax-L through the UK regulatory system. As the technology moves from "In Development" to a formal NICE decision, a "conditional" recommendation for early use (the EVA) would make it eligible for this multi-million-pound funding stream to support its rollout across NHS trusts" (Gemini AI Analysis - continued below) The link provided refers to a specific National Institute for Health and Care Excellence (NICE) Early Value Assessment (EVA) and a related funding call from the National Institute for Health and Care Research (NIHR). Specifically, the NIHR i4i PDA RWE NICE EVA (Invention for Innovation, Product Development Award, Real-World Evidence) is a specialized funding stream designed to bridge the "evidence gap" for promising medical technologies.The importance and synergy of this specific funding and regulatory framework to the DCVax platform technology (Northwest Biotherapeutics) are significant. Below is an analysis of how these elements intersect:1. Importance: Bridging the "Evidence Gap"The primary hurdle for personalized immunotherapies like DCVax-L is moving from clinical trial success to routine National Health Service (NHS) reimbursement.The Funding's Purpose: This NIHR call specifically funds the collection of Real-World Evidence (RWE). This is data gathered from patients treated in everyday clinical practice rather than a strictly controlled trial.Relevance to DCVax: Since DCVax-L has already shown significant survival benefits in its Phase III trial, the next hurdle is "commissioning." NICE often issues "conditional recommendations" through the EVA process, meaning they believe the tech is promising but need more data on cost-effectiveness and long-term real-world performance before full rollout. This funding allows companies to gather that data without the financial burden falling entirely on the developer or the individual NHS trusts.2. Synergy: NICE EVA and DCVax’s PotentialThe NICE Early Value Assessment (EVA) is a rapid review process for innovative technologies that address unmet needs.Accelerated Access: If DCVax-L were to enter the EVA pathway, it could receive a recommendation for use in the NHS while further evidence is being generated. This creates a "synergy" where patients get access years earlier than the traditional multi-year NICE appraisal process.Platform Potential: DCVax is not just a single drug; it is a platform technology. Because it uses the patient's own tumor antigens, it can theoretically be adapted for any solid tumor (Direct, Prostate, etc.). A successful RWE project for Glioblastoma (the lead indication) creates a regulatory and evidentiary "blueprint" that could be applied to other cancers in the DCVax pipeline.3. Relevance: The Strategic "Fit"The April 2026 funding call is highly relevant to DCVax for three reasons:Cost-Effectiveness: Personalized medicines are expensive to manufacture. The NIHR/NICE synergy focuses heavily on "health economic cases." This funding supports the creation of the economic models required to prove that the high upfront cost of DCVax is offset by long-term survival and reduced need for end-of-life care.Analytical Partnerships: The call requires an "Analytical Partner" (usually a university or specialist CRO) to lead the evidence generation. This is ideal for a mid-sized biotech like Northwest Biotherapeutics, as it provides external validation of their data by UK academic institutions.UK as a Testbed: The UK's Life Sciences Vision aims to make the NHS a "leading testbed" for late-stage innovations. For a US-based company like Northwest Biotherapeutics, utilizing this UK framework provides a "gold-standard" stamp of approval from NICE, which is often used as a benchmark by other international health regulators. In short, the April 2026 call represents a commercial and regulatory "on-ramp" for the DCVax technology to move from a successful clinical trial asset to a standard-of-care treatment within the UK healthcare system. nihr.ac.uk/funding/i4i-pd… he NIHR funding call you referenced (i4i PDA RWE NICE EVA April 2026) has high theoretical relevance to Northwest Biotherapeutics' DCVax® platform technology, specifically because it is designed to fund the exact type of evidence generation that DCVax-L currently requires for UK adoption. Here is the breakdown of why this is relevant: 1. The Funding Purpose: Filling the "Evidence Gap" The specific aim of this NIHR (National Institute for Health and Care Research) call is to provide funding for technologies that have received a NICE Early Value Assessment (EVA) recommendation. What it does: It funds the generation of Real-World Evidence (RWE) to address uncertainties identified by NICE. Relevance to DCVax: DCVax-L is currently undergoing a NICE Single Technology Appraisal (ID836) for treating glioblastoma. If NICE decides that the current clinical trial data is promising but needs more "real-world" validation before a full recommendation, they often move the technology into the EVA pathway. This NIHR grant would then be the primary mechanism to pay for that data collection within the NHS. 2. Alignment with DCVax’s Regulatory Status The DCVax platform is a personalized immunotherapy. For such "disruptive" technologies, health regulators like NICE often struggle with "long-tail" data—how patients fare over many years in a standard hospital setting compared to a controlled trial. The NIHR call explicitly asks for analytical partners and technology partners (like NW Bio) to team up with NHS adopting sites. This matches NW Bio’s stated strategy of seeking ways to make DCVax available to UK patients through the NHS while simultaneously collecting the data required for full reimbursement. 3. Addressing the "Health Economic Case" A major hurdle for DCVax has been the cost-benefit analysis (Health Economics). This NIHR call specifically requires applicants to: Outline a clear health economic case. Describe how the technology reduces mortality or improves quality of life compared to existing NHS pathways (e.g., the Stupp Protocol). Funding from this grant (up to 36 months) would allow the company to prove that DCVax reduces the long-term burden on the NHS, potentially justifying its price point. 4. Strategic Timing The timing of this call (opening April 2026) aligns with the expected progression of DCVax-L through the UK regulatory system. As the technology moves from "In Development" to a formal NICE decision, a "conditional" recommendation for early use (the EVA) would make it eligible for this multi-million-pound funding stream to support its rollout across NHS trusts. In short: This funding is a "bridge" to help expensive, innovative technologies like DCVax get over the final hurdle of NHS cost-effectiveness hurdles by paying for the necessary real-world data collection

From today, the @MHRAgovuk-NICE Aligned Pathway is open, delivering parallel decisions on licencing and value to get medicines to NHS patients 3-6 months sooner. No separate application or fee needed for eligible topics. Learn more: nice.org.uk/news/blogs/mhr…


